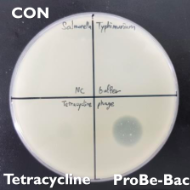

使用滅菌靈的優勢
由於台灣的畜牧業常態性的使用抗生素,不論是促進生長表現或者預防疾病的爆發,導致抗藥性的產生使得治療效果變差
滅菌靈通過獨家基因技術改良菌株(枯草桿菌)使其具備可以對抗、殺滅細菌的能力
根據現場實測證實可有效取代抗生素、抑菌蛋白、抗菌精油、酸化劑、益生菌來降低飼養成本,同時預防疾病爆發。
滅菌靈的特點與其他產品對比
跳脫傳統的思維框架,從不同的角度切入來處理問題

不產生抗藥性
抗生素的濫用最怕的就是抗藥性的生成,許多客戶送實驗室檢測發現已無抗生素對現場具備敏感度
但滅菌靈不存在這個問題!
__24F220Yhyq.jpg)
穩定度高
使用益菌蛋白、精油類型的產品穩定度是最大的疑慮,沒有良好的保存技術光是經過高溫製粒的過程就會受到破壞導致力價大幅減少

不增加肝臟壓力
使用抗生素、添加劑等登需要經由肝臟代謝,無形中增加器官壓力加速受損進而影響產能,此外抗生素的組合也需注意避免中毒的狀況發生

不破壞腸道菌群
額外添加的益生菌不一定適合個體腸道也需時間調整適應,使用滅菌靈並不會殺滅有益菌群反而可以創造更好的生存空間促進其增長
創新產品利用最尖端的技術結合可靠的學理基礎 (發表7篇論文51項專利) 開發獨特產品,不僅可以解決日益嚴峻的問題,也可幫助畜主、業者減少成本與損失
-

對於克痢黴素Colistin產生抗藥性之大腸桿菌,使用滅菌靈可消滅產生抗藥性之大腸桿菌因此左下角可出現透明環。長期使用可將現場藥物敏感度補救回來。
-
對於四環黴素Tetracycline產生抗藥性之沙門氏菌,使用滅菌靈可消滅產生抗藥性之沙門氏菌因此左下角可出現透明環。長期使用可將現場藥物敏感度補救回來。
客戶使用案例
-

糞便性狀改善
客戶原先因為水腫病導致豬隻暴斃死亡,使用抗生素治療效果不佳死亡不斷發生,添加滅菌靈後症狀解除並從人工乳後則無添加抗生素,比較三批個1000頭發現生長表現對比過往添加抗生素來的更好且成本更低。
-

消化能力提升-改善便秘
懷孕母豬後期容易出現便秘,會導致生產過程拉成不但給母豬造成負擔也會提升難產的風險,一般會添加纖維來改善但將面臨熱量過高母豬肥胖的短板。單純使用滅菌靈不更改配方即可有效改善,測試61隻僅有2隻出現便秘。
-

魚粉品質差-沙門氏菌症
此個案因為魚粉品質差導致沙門氏菌在中大豬這個階段爆發,下痢無法根除使用抗生素治療效果差,踩食量下降一天約莫少吃100公斤飼料。添加滅菌靈做治療第一週後下痢狀況根除,第二週踩食量回升正常水平。







